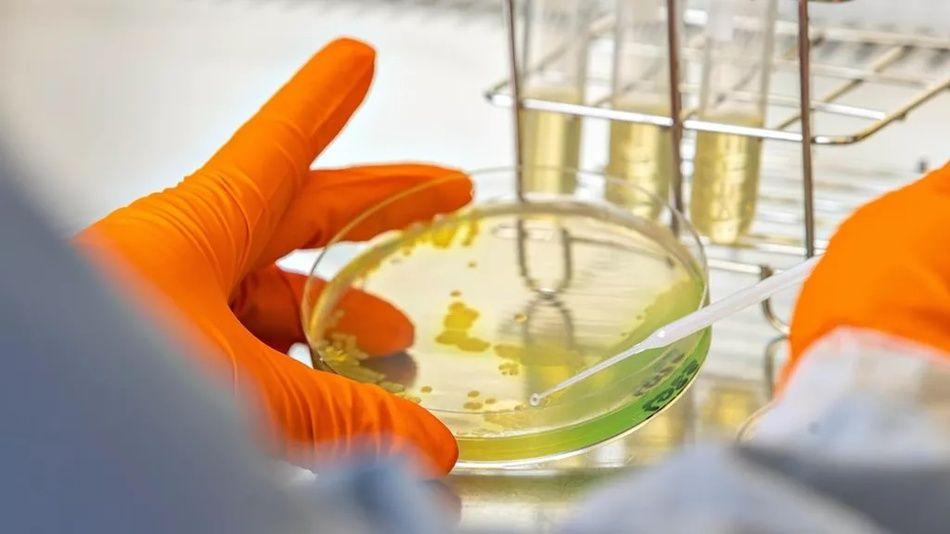
Antabio, spécialiste des traitements antibactériens, lève 25 M€

Antabio, une entreprise biopharmaceutique française, annonce une levée de fonds de 25 millions d’euros pour soutenir le développement d’un traitement antibactérien révolutionnaire.
Antabio, basée à Labège, en France, se spécialise dans le développement de traitements innovants contre les infections sévères résistantes aux antibiotiques. L’entreprise est reconnue pour son engagement envers la lutte contre la résistance aux antimicrobiens (AMR), un défi sanitaire mondial majeur. Selon l’Organisation Mondiale de la Santé, l’AMR a causé près de 5 millions de décès en 2019 et pourrait entraîner plus de 10 millions de morts par an d'ici 2050.
Parmi ses produits phares, on trouve MEM-ANT3310, un traitement antibactérien de nouvelle génération ciblant les pathogènes à Gram-négatif résistants, essentiel dans le traitement des infections nosocomiales critiques, telles que les pneumonies acquises à l'hôpital.
Une levée de fonds pour compléter des études cliniques
La récente levée de fonds de 25 millions d’euros marque un tournant pour Antabio. Ce financement, provenant de l’AMR Action Fund, du Fonds EIC, et de partenaires fidèles tels que BNP Paribas Développement, Relyens Innovation Santé / Turenne Capital, IRDI Capital Investissement et Christophe Ricard, va permettre de compléter les études cliniques de Phase 2 de MEM-ANT3310, un traitement prometteur contre des bactéries résistantes.
Marc Lemonnier, Directeur Général et fondateur d’Antabio, se félicite de cette réussite dans un communiqué de presse : “Réussir une levée de fonds aussi significative en cette période historiquement difficile pour le secteur est un accomplissement exceptionnel et une affirmation de notre vision, de notre équipe et de notre portefeuille de produits innovants.”
Avec ce nouveau financement, la jeune pousse se positionne comme un acteur clé dans la lutte contre l’AMR. Leur approche innovante pourrait radicalement changer le traitement des infections résistantes aux antibiotiques et représente un espoir pour des millions de patients dans le monde.